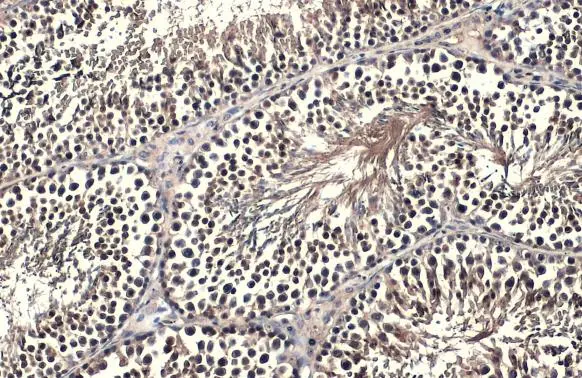
FOXO1 antibody detects FOXO1 protein at nucleus by immunohistochemical analysis. Sample: Paraffin-embedded mouse testis. FOXO1 stained by FOXO1 antibody (GTX135251) diluted at 1:5000. Antigen Retrieval: Citrate buffer, pH 6.0, 15 min

FOXO1 antibody detects FOXO1 protein at cytoplasm and nucleus in mouse testis by immunohistochemical analysis. Sample: Paraffin-embedded mouse testis. FOXO1 antibody (GTX130279) diluted at 1:500.
Antigen Retrieval: Citrate buffer, pH 6.0, 15 min
FOXO1 antibody
GTX130279
ApplicationsImmunoHistoChemistry, ImmunoHistoChemistry Paraffin
Product group Antibodies
ReactivityHuman, Mouse
TargetFOXO1
Overview
- SupplierGeneTex
- Product NameFOXO1 antibody
- Delivery Days Customer9
- Application Supplier NoteIHC-P: 1:100-1:1000. *Optimal dilutions/concentrations should be determined by the researcher.Not tested in other applications.
- ApplicationsImmunoHistoChemistry, ImmunoHistoChemistry Paraffin
- CertificationResearch Use Only
- ClonalityPolyclonal
- Concentration2.13 mg/ml
- ConjugateUnconjugated
- Gene ID2308
- Target nameFOXO1
- Target descriptionforkhead box O1
- Target synonymsFKH1, FKHR, FOXO1A, forkhead box protein O1, forkhead box protein O1A, forkhead, Drosophila, homolog of, in rhabdomyosarcoma
- HostRabbit
- IsotypeIgG
- Protein IDQ12778
- Protein NameForkhead box protein O1
- Scientific DescriptionThis gene belongs to the forkhead family of transcription factors which are characterized by a distinct forkhead domain. The specific function of this gene has not yet been determined; however, it may play a role in myogenic growth and differentiation. Translocation of this gene with PAX3 has been associated with alveolar rhabdomyosarcoma. [provided by RefSeq]
- ReactivityHuman, Mouse
- Storage Instruction-20°C or -80°C,2°C to 8°C
- UNSPSC12352203